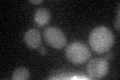
YLR160C
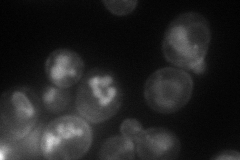
YLR160C
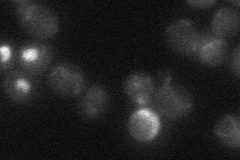
YLR160C
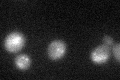
YLR160C
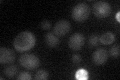
YLR160C

View description
Cell-wall L-asparaginase II, involved in asparagine catabolism; expression is induced during nitrogen starvation; four copies of ASP3 are present in the genome reference strain S288C
Localization:
Intensity:
Fold change:
Significance:
-
C’ GFP library in SD
below threshold13.29 -
N' NOP1pr-GFP in SD
cell periphery,vacuole75.8092 -
N' TEF2pr-mCherry in SD

ER,vacuole15.8645 -
N' NATIVEpr-GFP in SD
below threshold18.7788 -
N' TEF2pr-VC and Cyto-VN in SD

#N/A0 -
C’ GFP library in SD+DTT
cytosol17.051.28No -
C’ GFP library in SD+H2O2

cytosol17.081.28No -
C’ GFP library in Starvation Media
cytosol23.491.76No -
C’ GFP library on the background of Pup2-DaMP

below threshold -
C’ GFP library on the background of CCT mutant

below threshold16.09931.21091No
